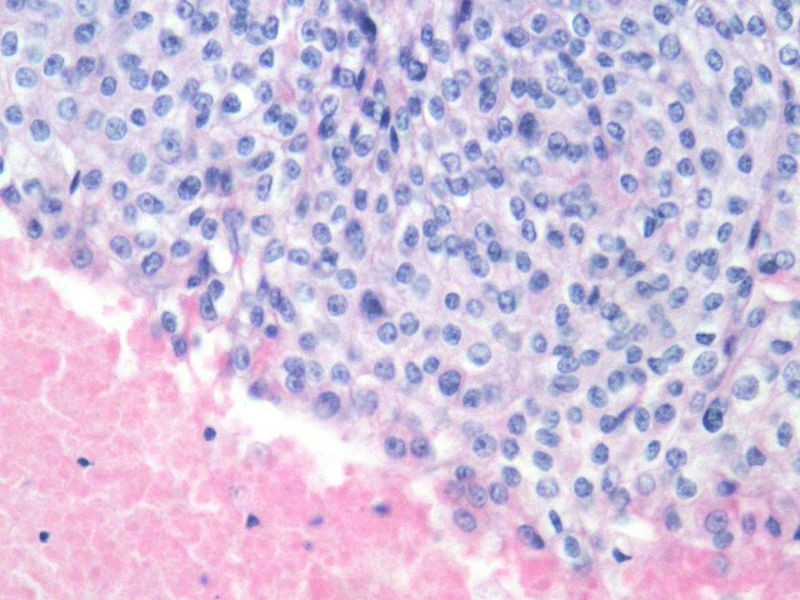
脑左颞部占位图5
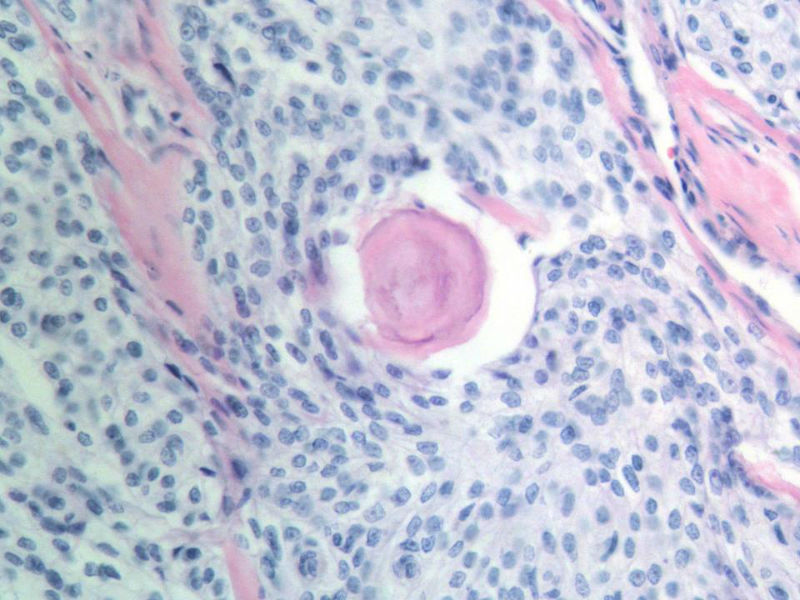
脑左颞部占位图8
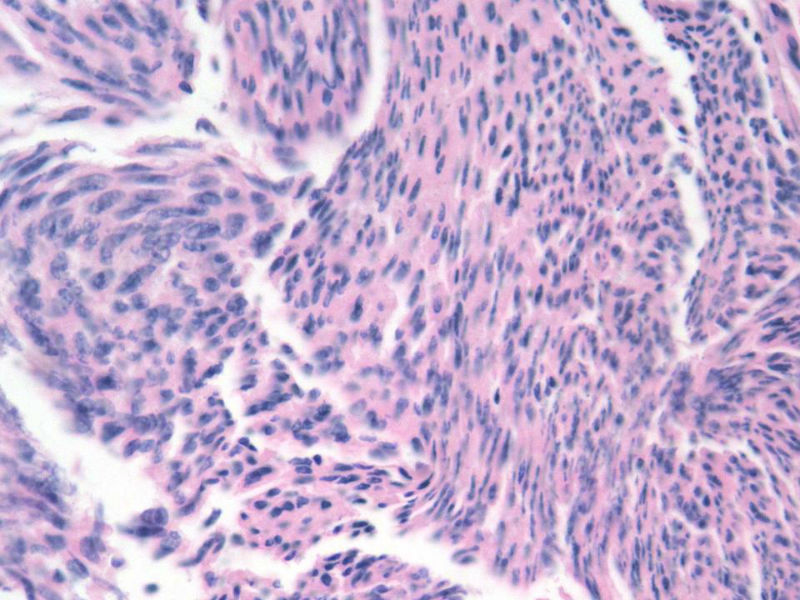
脑左颞部占位图12

| 图片: | |
|---|---|
| 名称: | |
| 描述: | |
- 脑左颞部占位
女,64岁,头晕半月,CT检查颅内左颞叶占位,侵犯颅骨和颞肌,手术切除肿物。肉眼,灰白色结节状肿物,3X3X2厘米,边界不清,切面灰黄色,质软。
特别提示:手术前曾做过介入肿瘤栓塞。镜下核分裂15/HP。
名称:图1
描述:幻灯片2
描述:幻灯片2

名称:图2
描述:幻灯片3

名称:图3
描述:幻灯片4

名称:图4
描述:幻灯片5
名称:图5
描述:幻灯片6

名称:图6
描述:幻灯片7

名称:图7
描述:幻灯片8
名称:图8
描述:幻灯片9

名称:图9
描述:幻灯片10

名称:图10
描述:幻灯片11

名称:图11
描述:幻灯片12
名称:图12
描述:幻灯片13

名称:图13
描述:幻灯片14

名称:图14
描述:幻灯片15

名称:图15
描述:幻灯片16

名称:图16
描述:幻灯片17

名称:图17
描述:幻灯片18

名称:图18
描述:幻灯片19

名称:图19
描述:幻灯片20
标签:
-
本帖最后由 xclbljys 于 2011-11-08 07:22:07 编辑

- 许春雷
×参考诊断
-
wangdingding 离线
- 帖子:1474
- 粉蓝豆:98
- 经验:6042
- 注册时间:2006-10-19
- 加关注 | 发消息


















